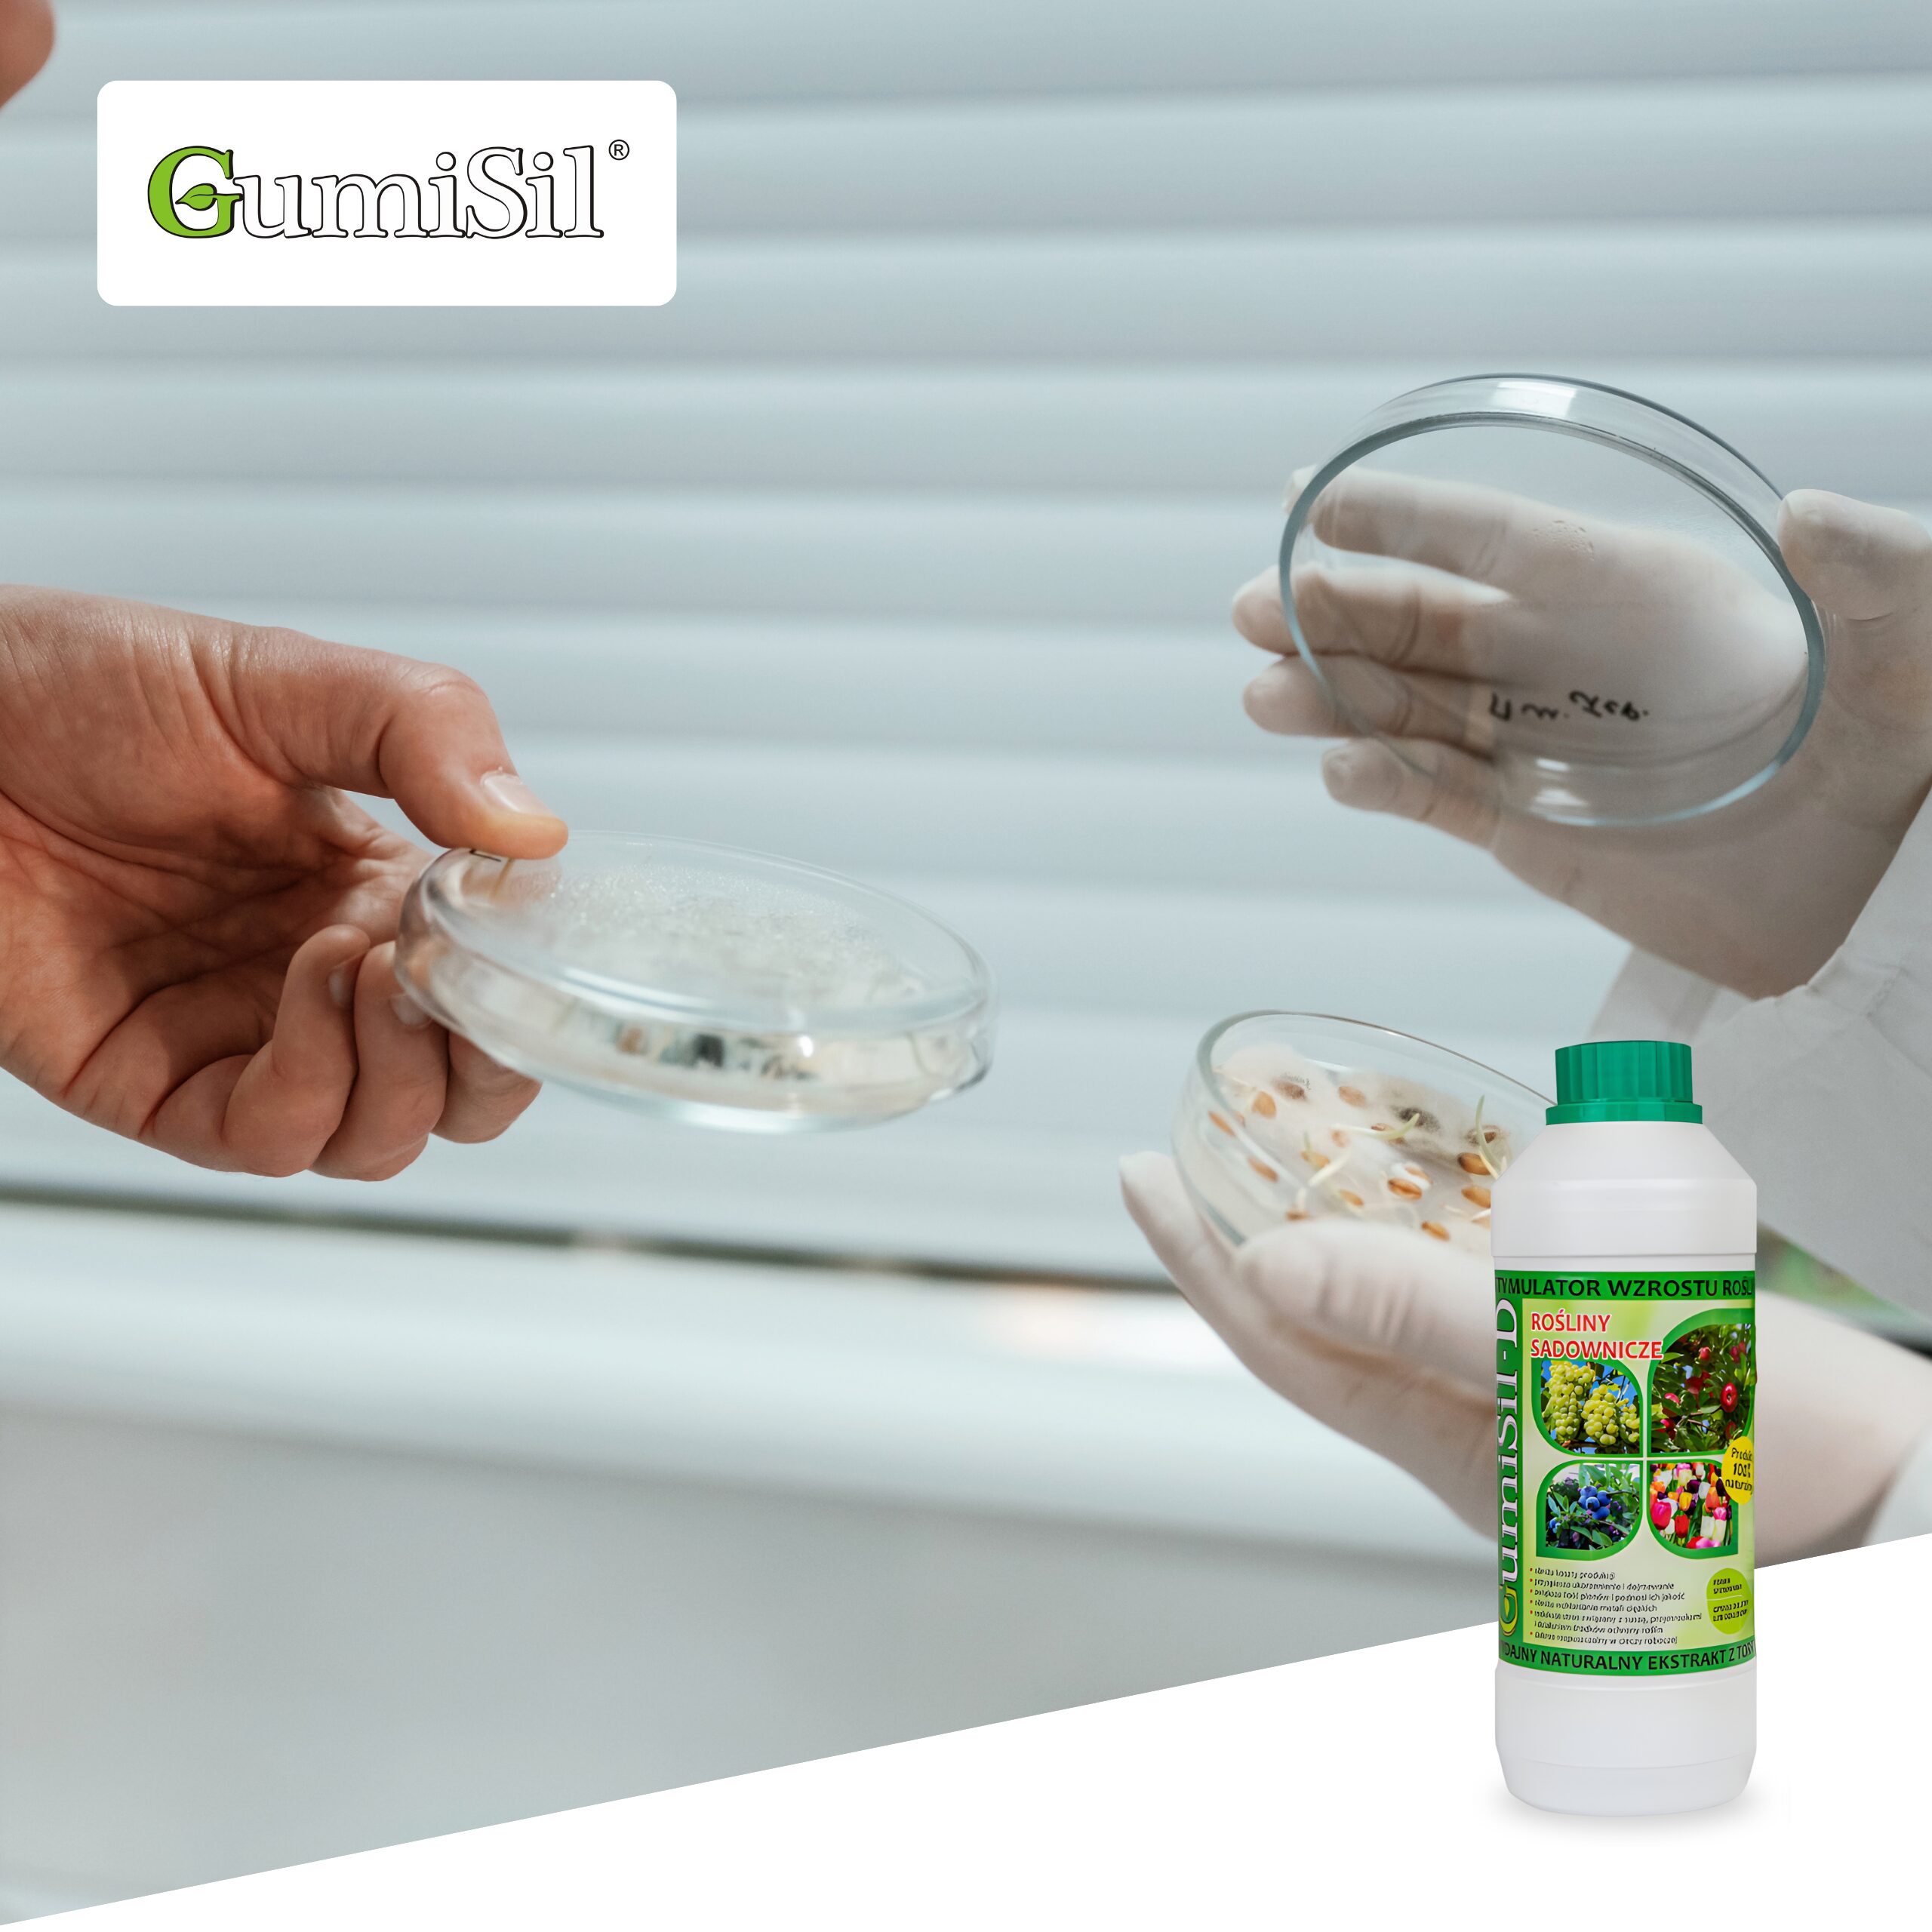

SKLEP PRODUCENTA
GumiSil-D 1L – Stymulator Wzrostu do Owoców, Krzewów i Kwiatów | Trichoderma | Bakterie PGPR | Większy Plon
GumiSil-D to organiczno-mineralny, ekologiczny stymulator wzrostu przeznaczony do roślin sadowniczych, jagodowych, kwiatów ozdobnych oraz ziół. Doskonale sprawdza się m.in. w uprawie malin, truskawek, borówek, winorośli, drzew owocowych, a także roślin ozdobnych ogrodowych i domowych. Preparat bazuje wyłącznie na naturalnych składnikach aktywnych, które wspierają rozwój roślin od fazy ukorzeniania aż po owocowanie i kwitnienie.
Zawiera kwasy humusowe i fulwowe, mikro- i makroelementy, aminokwasy, witaminy, fitohormony, a przede wszystkim pożyteczne grzyby Trichoderma oraz bakterie PGPR, które intensywnie rozwijają system korzeniowy, poprawiają pobieranie składników pokarmowych oraz zwiększają odporność roślin na stres i choroby odglebowe.
Preparat przeznaczony do stosowania dolistnego i doglebowego, bezpieczny dla roślin, gleby i środowiska.
Zezwolenie do stosowania w rolnictwie ekologicznym – nr SE/16/2018.
Zastosowanie – uprawy:
- maliny, truskawki, borówki, jagody
- winorośl
- jabłonie, grusze, śliwy, wiśnie, pigwa
- krzewy owocowe i sadownicze
- kwiaty ozdobne (ogród i dom)
- zioła
Możliwość stosowania:
- oprysk dolistny
- zabiegi doglebowe
- moczenie sadzonek przed sadzeniem
- pożywka
Najważniejsze korzyści stosowania GumiSil-D:
- intensywny przyrost latorośli i pędów
- zwiększenie liczby zawiązanych owoców
- wyższa zawartość cukrów w owocach
- lepsza jakość i wyrównanie plonu
- poprawa gospodarki wodnej
- zwiększona odporność na stres termiczny i po ŚOR
- wzmocnienie pąków kwiatowych
- redukcja azotanów
- ograniczenie wchłaniania metali ciężkich
- szybsze ukorzenienie i dojrzewanie roślin
Skład i działanie:
- Grzyby Trichoderma – kolonizują strefę korzeniową, konkurują z patogenami (Fusarium, Phytophthora, Rhizoctonia, Sclerotinia, Pythium), zwiększają dostępność składników
- Bakterie PGPR – produkują naturalne fitohormony (auksyny, gibereliny, cytokininy), stymulują wzrost i odporność
- Kwasy humusowe i fulwowe – poprawiają strukturę gleby i przyswajalność składników
- Aminokwasy i witaminy – wspierają metabolizm i regenerację
- NPK (95 g/l : 45 g/l : 100 g/l) + mikroelementy – kompleksowe odżywienie
Preparat działa biologicznie i naturalnie, stanowiąc uzupełnienie integrowanej ochrony roślin.
Dawkowanie i zalecenia:
- Drzewa owocowe (jabłoń, grusza, śliwa, wiśnia):
moczenie sadzonek: 350 ml / 100 l wody
zabiegi doglebowe: 300–500 ml / 100 l wody
pąki kwiatowe i po kwitnieniu: 300 ml / 100 l wody
- Malina, truskawka, borówka, winorośl:
1–2,5 l / ha w 300–800 l wody
(2 tyg. przed kwitnieniem, początek kwitnienia, 2 tyg. po kwitnieniu)
- Rośliny ozdobne i zioła:
300 ml / 100 l wody
- Pożywka:
0,4–0,5% (4–5 l / 1000 l wody)
do 1% w warunkach stresowych
Dlaczego warto wybrać GumiSil-D?
- produkt EKO – bez chemii
- naturalne wsparcie owocowania i kwitnienia
- silny system korzeniowy
- większy i lepszej jakości plon
- sprawdzona skuteczność w praktyce
GumiSil-D to kompleksowe, biologiczne wsparcie dla owoców, krzewów i roślin ozdobnych.
✅ Zamów teraz i postaw na zdrowe, plonujące rośliny! ?
Poznaj całą linię GumiSil
W naszej ofercie znajdziesz również inne warianty dopasowane do rodzaju uprawy:
- GumiSil-A – zboża ozime i jare
- GumiSil-B – rośliny przemysłowe, oleiste oraz kukurydza
- GumiSil-C – warzywa i rośliny okopowe
- GumiSil-D – rośliny sadownicze
➡️ Sprawdź nasze pozostałe aukcje i dobierz odpowiedni preparat do swoich upraw!